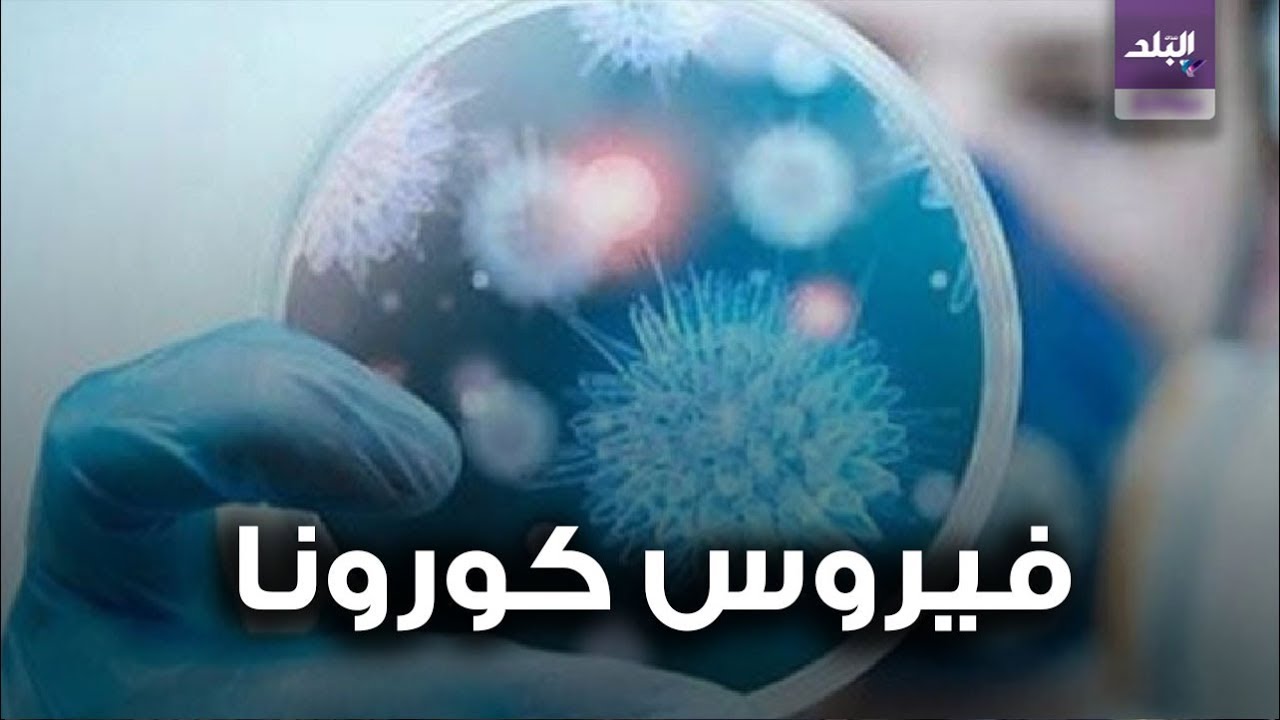
فيروس كورونا - صورة تعبيرية

قال كريستيان لودمير، المتحدث باسم منظمة الصحة العالمية، إنه لا توجد أية حالة إصابة مؤكدة بفيروس "كورونا" الجديد مبلغ عنها بدول القارة الأفريقية، مؤكدا أنه برغم ذلك يجب أن تتخذ كافة الدول الاحتياطات الكافية والاستعدادات من مراقبة وتأهب ورصد على مستوى العالم.
ونوه "لودمير" في مؤتمر صحفي اليوم الثلاثاء في جنيف "ردا على سؤال حول استعدادات بعض الدول لإجلاء رعاياها من إقليم ووهان الصيني الذي انتشر فيه الفيروس" بأن المنظمة الدولية لم تتخذ بعد قرارا بشأن موضوع الإجلاء حتى تحصل على مزيد من المعلومات عن هوية الفيروس وطرق انتشاره والإصابة به ، لافتا إلى أن المدير العام للمنظمة الدولية الدكتور تيدروس أدهانوم "الذي توجه إلى الصين" يبحث مع المسؤوليين الصينيين الأوضاع هناك و مدى خطورة الفيروس وانتشاره.
وأكد أن عدد حالات الوفيات مقارنة مع الأعداد المصابة بالفيروس مازالت منخفضة، منوها بأنه حتى الآن معظم من يعانون من الإصابة بالفيروس إما لديهم ظروف صحية خاصة أو من كبار السن.
وفي سياق متصل ، أعلنت السلطات التركية اليوم الثلاثاء نقلها 9 سياح صينيين ومواطنين تركيين، إلى أحد المستشفيات لإجراء الفحوص اللازمة، وذلك بعد الاشتباه في إصابتهم بفيروس "كورونا".
وقال حاكم مدينة "أكساري" السياحية، علي "مانتي" وفقا لقناة "روسيا اليوم" الإخبارية - "إن أعراض الإصابة بفيروس كورونا بدت على أحد السياح، وفي إطار الاحتياطات الطبية الوقائية، قرر الأطباء عزل 9 أشخاص كانوا متواجدين معه، بالإضافة إلى الدليل السياحي وسائق الحافلة".
وأوضح أنه تم إرسال العينات التي أخذت من المشتبه بإصابتهم بفيروس "كورونا" إلى وزارة الصحة، والاحتفاظ بكل الأشخاص في جناح خاص معقم في المستشفى حتى معرفة نتائج التحليل.
وكانت السلطات الصينية قد أعلنت في وقت سابق اليوم، ارتفاع عدد القتلى والمصابين بالفيروس الجديد، حيث بلغت حالات الوفيات 106 أشخاص، وتجاوز عدد المصابين 4 آلاف مصاب، فيما تم تسجيل عشرات الإصابات في دول أخرى، مثل اليابان، والولايات المتحدة وفيتنام، وتايلاند، وفرنسا، وألمانيا، وسنغافورة، ونيبال، وأستراليا، وكندا.